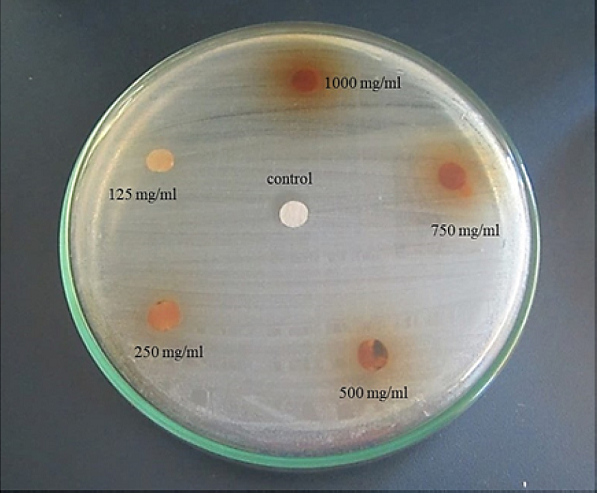
Halos inhibitorios E. coli
ocasionados por el extracto etan&oacute;lico de A. muricata

Artículos Originales
Efecto antibacteriano del extracto etanólico de Annona muricata sobre microorganismos de importancia clínica
Gaceta Médica Boliviana
Universidad Mayor de San Simón, Bolivia
ISSN: 1012-2966
ISSN-e: 2227-3662
Periodicidad: Semestral
vol. 44, núm. 1, 2021
Recepción: 10 Marzo 2021
Aprobación: 12 Mayo 2021
Resumen:
El incremento de cepas patógenas resistentes a fármacos convencionales ha limitado las opciones de tratamiento médico. Ante ello surge la necesidad de buscar alternativas terapéuticas. Muchas especies vegetales poseen enorme potencial antimicrobiano que puede ser de gran utilidad. Objetivo: determinar el efecto antibacteriano in vitro del extracto etanólico de Annona muricata L. sobre Staphylococcus aureus, Streptococcus B – hemolíticos y Escherichia coli.
Métodos: se evaluaron 135 unidades experimentales conformadas por 3 cepas de Staphylococcus aureus, Streptococcus B-hemolíticos y Escherichia coli, además de 5 concentraciones del extracto y 3 repeticiones del experimento. Para determinar el efecto antibacteriano in vitro se emplearon los métodos de disco difusión en agar y macrodilución en caldo. Se utilizó el extracto etanólico a concentraciones de 125, 250, 500, 750, 1000 mg/ml y solución salina fisiológica estéril como control negativo.
Resultados: el extracto inhibió el crecimiento in vitro de Staphylococcus aureus y Streptococcus B-hemolíticos. La mayor inhibición se observó a 1 000 mg/ml con halos inhibitorios de 14,6 mm y 12,33 mm de diámetro, respectivamente. Para Escherichia coli no se observó la formación de halos inhibitorios. Las cepas de Streptococcus B-hemolíticos y Staphylococcus aureus presentaron una concentración mínima inhibitoria de 250 y 500 mg/ml, respectivamente.
Conclusión: el efecto antibacteriano in vitro fue directamente proporcional a cada concentración empleada sobre Staphylococcus aureus y Streptococcus B-hemolíticos. En el caso Escherichia coli no se observó inhibición de crecimiento.
Palabras clave: annona muricata, staphylococcus aureus, streptococcus, escherichia coli, plantas medicinales, extractos vegetales.
Abstract:
The increase in pathogenic strains resistant to conventional drugs has limited medical treatment options. Given this, the need to seek therapeutic alternatives arises. Many plant species have enormous antimicrobial potential that can be very useful. Objective: to determine in vitro the antibacterial effect of the ethanolic extract of Annona muricata L. on Staphylococcus aureus, Streptococcus B - hemolytic and Escherichia coli.
Methods: 135 experimental units were evaluated, consisting of 3 strains of Staphylococcus aureus, Streptococcus B-hemolytic and Escherichia coli, in addition to 5 concentrations of the extract and 3 repetitions of the experiment. To determine the antibacterial effect in vitro, the agar diffusion disk and broth macrodilution methods were used. The ethanolic extract was used at concentrations of 125, 250, 500, 750, 1000 mg / ml and sterile physiological saline solution as negative control.
Results: the extract inhibited in vitro growth of Staphylococcus aureus and Streptococcus B-hemolytic. The greatest inhibition was observed at 1000 mg / ml with inhibitory halos of 14.6 mm and 12.33 mm in diameter, respectively. For Escherichia coli the formation of inhibitory halos was not observed. The Streptococcus B-hemolytic and Staphylococcus aureus strains presented a minimum inhibitory concentration of 250 and 500 mg / ml, respectively.
Conclusion: the in vitro antibacterial effect was directly proportional to each concentration used on the Staphylococcus aureus and Streptococcus B-hemolytic. In the case of Escherichia coli, no growth inhibition was observed.
Keywords: annona muricata, staphylococcus aureus, streptococcus, escherichia coli, medicinal plants, plant extracts.
La aparición de microorganismos que presentan genes de resistencia a diferentes fármacos sintéticos, es un problema cada vez más recurrente. Estos mecanismos de resistencia que son codificados a nivel de cromosomas o plásmidos conducen a la ineficacia del tratamiento e incrementan el costo destinado a la recuperación del paciente1,2.
Un ejemplo lo constituye Staphlylococcus aureus, un coco Gram positivo comúnmente encontrado en el medio hospitalario e involucrado en numerosas infecciones nosocomiales, principalmente en pacientes inmunodeprimidos. Produce cuadros infecciosos y toxigénicos a nivel cutáneo, de mucosas, pleuropulmonares, entre otros 3. La aparición y propagación del S. aureus resistente a la meticilina limita aún más las opciones de tratamiento4.
Otros patógenos Gram positivos que han generado resistencia a los antibióticos son los Streptococcus β - hemolíticos del Grupo A. Estas bacterias son causantes de la faringoamigdalitis aguda y otras infecciones de tipo sistémicas (fiebre reumática, glomerulonefritis postestreptocócica y endocarditis)5. Así también Escherichia coli es un patógeno bacteriano que predomina en la microbiota intestinal. Usualmente esta presente de forma inocua, pero puede llegar a ocasionar infecciones entéricas, diarreicas y urinarias6. Este microorganismo Gram negativo ocasiona la mayoría de infecciones urinarias comunitarias. El alarmante incremento de su resistencia antibiótica está asociado al uso desmedido de los antimicrobianos, lo que favorece a la síntesis de enzimas betalactamasas de espectro extendido7,8.
En Perú, el potencial farmacológico de las plantas ha despertado un gran interés. Se vienen realizando múltiples investigaciones cuya finalidad es corroborar los conocimientos de la medicina tradicional9. Así se encuentra Annona muricata L., un árbol que mide entre 5 y 10 m de longitud. Es conocido en Perú como guanábana y forma parte de la familia Annonaceae. Se le encuentra principalmente en zonas con climas tropicales como el centro y sur de América, de donde es originario 10. Sus hojas son utilizadas empíricamente por sus propiedades antiparasitarias, antibacterianas, antidiarreicas, antiglicémicas y antitumorales10,11. Estudios de caracterización fitoquímica de sus hojas han demostrado la presencia de polifenoles, esteroides, alcaloides (muricina y muricinina), taninos, flavonoides, saponinas y acetogeninas11,12.
De modo que la guanábana posee un gran potencial fitomedicinal, lo que fomenta la realización de nuevos estudios que permitan contribuir al conocimiento de sus propiedades ya reportadas. Asimismo, buscar terapias alternativas para controlar las infecciones ocasionadas por patógenos de importancia clínica. Sobre todo, si se considera la creciente capacidad de desarrollar resistencia a muchos de los medicamentos convencionales. Ante ello se planteó como objetivo determinar el efecto antibacteriano in vitro del extracto etanólico de Annona muricata L. frente a Staphylococcus aureus, Streptococcus B – hemolíticos y Escherichia coli.
Material y métodos
El estudio fue experimental de estímulo creciente cuya población estuvo constituida por cepas de S. aureus, St. B – hemolíticos y E. coli. La muestra estuvo conformada por 135 unidades experimentales (3 cepas de S. aureus, 3 cepas de St. B-hemolíticos y 3 cepas de E. coli, 5 concentraciones del extracto, 3 repeticiones). Las cepas bacterianas fueron proporcionadas por el cepario del laboratorio de Microbiología de la Universidad Nacional Pedro Ruiz Gallo situada en la avenida Juan XXIII 391, provincia de Lambayeque, departamento de Lambayeque, Perú.
Las hojas de A. muricata se recolectaron en el distrito de Monsefú, provincia de Chiclayo, departamento de Lambayeque, Perú (6°52´55´´S 79°52´11´´O) a 11ms.n.m. Un espécimen vegetal completo fue trasladado al Herbario Pedro Ruiz Gallo para su identificación, caracterización y certificación (Código de registro N° 17883).
Preparación del extracto etanólico A. muricata
Antes de iniciar el proceso se desinfectó las hojas de guanábana con hipoclorito de sodio al 2% y enseguida se utilizó agua destilada estéril para enjuagarlas. Se deshidrataron 3 kg de hojas manteniéndose en el horno a una temperatura de 60ºC durante 72 horas. El material vegetal seco fue triturado utilizando un mortero.
Las hojas pulverizadas y pesadas se colocaron dentro de un vaso de precipitación estéril conteniendo etanol al 96o como solvente (1:2 m/v). El preparado se dejó macerar realizando continuamente movimientos rotacionales a temperatura ambiental y sin mantener contacto directo con la luz solar. Después de 7 días, se filtró el producto tres veces con papel para filtrar Whatman N°1.
El extracto total se llevó al rotavapor para obtener el extracto seco. Al extracto seco se le adicionó etanol al 40º (1:1 m/v), obteniéndose la solución madre de 1000 mg/ml. Con la solución madre se realizaron concentraciones a 125, 250, 500, 750, 1000 mg/ml. Cada concentración se colocó en un vial estéril refrigerándose hasta iniciar el experimento.
Susceptibilidad antibacteriana mediante disco difusión en agar
Se emplearon cajas Petri conteniendo agar Müller-Hinton con previo control de esterilidad. Los inóculos bacterianos fueron sembrados por separado utilizando hisopos estériles (dispersión en la superficie de las placas). Los discos estériles fueron embebidos con el extracto etanólico a 125, 250, 500, 750, 1000 mg/ml y la solución salina fisiológica estéril (control negativo). Se secaron en el interior de una cabina de bioseguridad Nivel II. Cada disco se colocó sobre el agar a una distancia promedio de 20 mm entre sí y se dejaron reposar por 15 minutos, para luego incubarse a 37°C por 24 horas. Transcurridas las 24 horas, se midió la longitud de las zonas de inhibición observadas incluyéndose el diámetro del disco (mm)13.
Concentración mínima inhibitoria (CMI) mediante la macrodilución en caldo
El método macrodilución en caldo se realizó según lo establecido por el Instituto Nacional de Salud del Perú (Norma Técnica N° 30). Se empleó una batería de doce tubos de ensayo estériles, donde el tubo Nº11 sirvió como un control positivo (inóculo bacteriano) y el tubo Nº12 como control negativo (sin crecimiento). Los tubos fueron incubados a 35ºC durante 16 – 20 horas, para luego determinar la CMI. Dicho valor se obtuvo teniendo en cuenta el tubo con ausencia de turbidez al compararse con control negativo.
Análisis estadístico
Los datos obtenidos fueron tabulados y analizados con el software Minitab® 18 para Windows® versión 8. El Análisis de Varianza (ANOVA) se aplicó para comparar la inhibición bacteriana obtenida con cada concentración del extracto y con las cepas utilizadas. Asimismo, se realizó el test de Tukey para determinar el efecto del extracto a diferentes concentraciones sobre S. aureus y St. B-hemolíticos.
Resultados
Se evaluaron 5 concentraciones del extracto etanólico (125, 250, 500, 750 y 1 000 mg/ml). El diámetro de las zonas inhibitorias de S. aureus y St. B-hemolíticos presentó una creciente tendencia considerando las concentraciones utilizadas.
La concentración de 1000 mg/ml logró mayor inhibición de S. aureus y St. B-hemolíticos observándose halos inhibitorios de 12,33 mm y 14,66 mm, respectivamente (Tabla 1).
| Concentraciones del extracto (mg/mL) | Promedio de los Halos inhibitorios (mm) | ||
| S. aureus | St. B - hemolíticos | E. coli | |
| 125 | 5,00 | 7,88 | No presentó |
| 250 | 6,88 | 10,44 | No presentó |
| 500 | 9,33 | 11,88 | No presentó |
| 750 | 10,77 | 13,22 | No presentó |
| 1000 | 12,33 | 14,66 | No presentó |
El extracto etanólico a 125, 250, 500, 750 y 1000 mg/ml inhibió el crecimiento de S. aureus (Figura 1) y St. B-hemolíticos (Figura 2).


La concentración de 125 mg/ml ocasionó zonas de inhibición de 5,00 y 7,88 mm, respectivamente. No se visualizó inhibición del crecimiento in vitro de E. coli
El Análisis de Varianza (ANOVA) evidenció diferencias significativas entre la inhibición de S. aureus y St. B-hemolíticos respecto a las concentraciones evaluadas (Tabla 2).
| Fuente de Variación | Suma de cuadrados (SC) | Grados de libertad (GL) | Cuadrados Medios (CM) | Prueba F | Probabilidad (p) |
| Cepa | 82,04 | 4 | 20,51 | 5,26 | <0,05 |
| Concentración | 1129,62 | 4 | 282,41 | 72,41 | <0,05 |
| Cepa * concentración | 35,29 | 16 | 2,21 | 0,57 | |
| Error | 234 | 60 | 3,9 |
La prueba de Tukey mostró que los diámetros promedio de los halos inhibitorios fueron directamente proporcionales al incremento de la concentración del extracto (Tabla 3).
| Cepas bacterianas | Halos de inhibición (mm) | Nivel de Significancia | |
| SA1 | 8 | A | |
| SA2 | 8,33 | A | |
| SA3 | 6,53 | B | |
| SBH1 | 10,67 | A | |
| SBH2 | 10,73 | A | |
| SBH3 | 8,73 | B | |
* Streptococcus B - hemolíticos (SBH1, SBH2, SBH3)
*Con letras iguales:No diferencias signicativas
*Con letras diferentes:Existen diferencias signicativas
Discusión
Se evaluó el efecto antibacteriano in vitro del extracto etanólico de A. muricata frente a S. aureus, St. B-hemolíticos y E. coli. Las cepas de S. aureus y St. B-hemolíticos fueron sensibles a las diferentes concentraciones del extracto, obteniéndose halos de inhibición de hasta 12,33mm y 14,66mm, respectivamente. Mientras que E. coli mostró resistencia al extracto (Tabla 1). Solo se evaluaron tres cepas de cada especie bacteriana, presentándose como limitación del estudio.
Las hojas de la guanábana poseen gran cantidad de principios activos con significativo potencial terapéutico. Se ha identificado flavonoides (kaenferol, morina, miricetina, quercetina) que se unen a enzimas, transportadores de hormonas e iones de hierro, cobre y zinc. Es decir, se comportan como antioxidantes que eliminan radicales libres y fomentan el transporte de electrones, lo que favorecería su efecto antimicrobiano y antiinflamatorio14.
Especies pertenecientes al género Annona poseen compuestos policétidos llamados acetogeninas, a los cuales también se les atribuye importantes propiedades antimicrobianas. Las acetogeninas ejercen su efecto a nivel del complejo NADH - ubiquinona oxidorreductasa, afectando el tránsito de iones cargados negativamente a través de la cadena respiratoria15. Dichos compuestos modulan la producción de ATP, gracias a los anillos tetrahidrofurano (THF) y γ-lactona que presentan. Además, bloquean las cascadas de protones y con ello la respiración celular, afectando la viabilidad de las células16.
Un estudio evidenció la acción de la acetogenina annonacina sobre una línea celular de carcinoma de vejiga, reportándose incrementos del sodio mitocondrial. Esto favorece la desgranulación de la membrana mitocondrial, dañando la estructura celular y desencadenando su muerte. Así también el incremento de proteínas plegadas a consecuencia de las Especies Reactivas del Oxígeno (ROS) liberadas. Esto ocurre producto de la síntesis de aductos “proteína-ROS” y activa la muerte celular17.
Resultados similares reportaron Abadie et al.18 al evaluar el extracto hidroalcohólico de A. muricata sobre S. aureus, P. aeruginosa y E. coli. Las cepas de S. aureus mostraron sensibilidad al extracto, registrándose halos inhibitorios de 11,05 mm de diámetro. Mientras que no se limitó el crecimiento in vitro de E. coli y P. aeruginosa.
Además, al evaluar el efecto inhibitorio del extracto metanólico de guanábana sobre diversas bacterias Gram positivas y negativas se demostró mayor inhibición de E. faecalis, S. typhimurium, B. subtilis, Klebsiella sp, E. coli y St. pyogenes.
Este fenómeno se explicaría en el hecho de que el extracto afecta el ciclo de crecimiento bacteriano e induce rápidamente la muerte celular, respecto al control empleado19,20. A diferencia de Solomon-Wisdom et al.20, en esta investigación no se observó susceptibilidad in vitro de E. coli. Esto puede ocurrir debido a la procedencia de las cepas y la aparición de especies microbianas cada vez más patógenas.
En este sentido diversos estudios han reportado mayor actividad inhibitoria de la guanábana frente a especies bacterianas Gram positivas. Caso contrario se observa con las especies Gram negativas donde se ha encontrado una notable resistencia, lo que coincide con esta investigación. Esto se debería a que presentan una pared celular con estructura de mayor complejidad. La membrana externa de naturaleza lipolisacárida y las porinas limitan el paso de los metabolitos secundarios. Los compuestos anfipáticos pueden actuar como bombas que impiden el ingreso de estos compuestos21. También influyen factores como el tipo de especie bacteriana, aparición de mutaciones, tiempo de desarrollo de la planta, condiciones del suelo donde crece, cantidad de componentes químicos extraídos22.
El análisis de varianza evidenció diferencias significativas entre los diámetros de las zonas inhibitorias de S. aureus y St. B-hemolíticos, las concentraciones del extracto y las interacciones producidas entre ambos. El efecto antibacteriano de A. muricata fue independiente del tipo de cepa bacteriana utilizado, observándose susceptibilidad a cada una de ellas (Tabla 2). Asimismo, con el test de Tukey se demostró una relación directamente proporcional a la concentración empleada y efecto antibacteriano (Tabla 3). Las cepas de St. B – hemolíticos y S. aureus presentaron una CMI de 250 y 500 mg/ml, respectivamente. En el caso de E. coli no se registró inhibición del crecimiento a las concentraciones evaluadas.
Las propiedades terapéuticas que posee de la guanábana, la convierten en una especie vegetal de gran utilidad para el desarrollo de fármacos. Por lo que en un futuro podría ser considerada como una alternativa viable y accesible ante el incesable incremento y diseminación de los patógenos bacterianos resistentes a múltiples fármacos usados convencionalmente.
En conclusión, el extracto etanólico elaborado a base de las hojas de A. muricata posee efecto antibacteriano frente a Staphylococcus aureus y Streptococcus B- hemolíticos. Sin embargo, no inhibió el crecimiento in vitro de Escherichia coli. Dicho efecto estuvo relacionado con la concentración del extracto observándose mayor inhibición a 1000 mg/ml.
Conflicto de intereses: los autores declaran que no existe conflicto de intereses.
Referencias
1. Serra MA. La resistencia microbiana en el contexto actual y la importancia del conocimiento y aplicación en la política antimicrobiana. Rev haban cienc méd. 2017; 16(3): 402-19.
2. World Health Organization. Anti-infective drug resistance surveillance and containment team. Estrategia mundial de la OMS para contener la resistencia a los antimicrobianos [Consultado 10 feb 2021] Ginebra: Organización Mundial de la Salud; 2001. Disponible en: https://apps.who.int/iris/handle/10665/67197
3. Tong SY, Davis JS, Eichenberger E, Holland TL, Fowler VG. Staphylococcus aureus infections: Epidemiology, pathophysiology, clinical manifestations, and management. Clin Microbiol 2015; 28 (3): 603-61.
4. Boswihi SS, Udo EE. Methicillin-resistant Staphylococcus aureus: An update on the epidemiology, treatment options and infection control [consultado 15 feb 2021]. Current Medicine Research and Practice 2018; 8(1): 18-24. Disponible en: https://doi.org/10.1016/j.cmrp.2018.01.001
5. Soria N, Guilart M, Guerrero C, Caridad M. Aislamiento del estreptococo beta-hemolítico en niños asintomáticos. MEDISAN 2017; 21(1): 43-51.
6. Canata MG, Navarro R, Velázquez G, Rivelli S, Rodríguez F, Céspedes A, et al. Caracterización molecular de factores de virulencia de aislados Escherichia coli obtenidas de heces de niños con gastoenteritis del Hospital Central de Instituto de Previsión Social en el 2012. Pediatr (Asunción). 2016; 43(1): 13-7.
7. Yábar MN, Curi-Pesantes B, Torres CA, Calderón-Anyosa R, Riveros M, Ochoa TJ. Multirresistencia y factores asociados a la presencia de betalactamasas de espectro extendido en cepas de Escherichia coli provenientes de urocultivos. Rev. perú. med. exp. Salud pública. 2017; 34(4): 660-5.
8. Expósito LM, Bermellón S, Lescaille L, Delgado N, Aliaga I. Resistencia antimicrobiana de la Escherichia coli en pacientes con infección del tracto urinario. Rev inf cient. 2019; 98(6): 755-64.
9. Mostacero J, Mejía F, Gamarra O. Fanerógamas del Perú: Taxonomía, utilidad y ecogeografía. Perú: Editorial CONCYTEC; 2009. p. 464
10. Gavamukulya Y, Wamunyokoli F, El-Shemy HA. Annona muricata: ¿La terapia natural para la mayoría de las enfermedades, incluido el cáncer, está creciendo en nuestro patio trasero? Una revisión sistemática de su historial de investigación y perspectivas futuras. Asian Pacific Journal of Tropical Medicine 2017; 10 (9): 835-48.
11. Leiva S, Gayoso G, Chang L. Annona muricata L. “guanábana” (Annonaceae), una fruta utilizada como alimento en el Perú prehispánico. Arnaldoa 2018; 25 (1): 127-40.
12. Poma EM, Requis ER, Gordillo GC, Fuertes CM. Estudio fitoquímico y actividad antiinflamatoria de la Annona muricata L. (guanábana) de cuzco. Ciencia e Investigación 2011; 14(2): 29-33.
13. Sacsaquispe R. Manual de procedimientos para la prueba de sensibilidad antimicrobiana por el método de Disco Difusión. Perú: Instituto Nacional de Salud. 2002.
14. Schlie-Guzmán MA, González-Esquinca AR, Luna-Cazáres LM. Las acetogeninas de Annonaceae: efecto antiproliferativo en líneas celulares neoplásicas. Boletín Latinoamericano y del Caribe de Plantas Medicinales y Aromáticas. 2009; 8(4): 245-57.
15. Moghadamtousi SZ, Fadaeinasab M, Nikzad S, Mohan G, Ali HM, Kadir, HA. Annona muricata (Annonaceae): una revisión de sus usos tradicionales, acetogeninas aisladas y actividades biológicas [consultado 15 feb 2021]. R Int J Mol Sci. 2015; 16 (7): 15625-58. Disponible en: https://doi.org/10.3390/ijms160715625
16. Masato A, Kubo A, Yamamoto S, Hatoh Y, Murai M, Hattori Y, et al. Dynamic function of the spacer region of acetogenins in the inhibition of bovine mitochondrial NADH-ubiquinone oxidoreductase (complex I) [consultado 15 feb 2021] Biochemistry (Mosc) 2008; 47(23): 6260-6. Disponible en: https://pubs.acs.org/doi/10.1021/bi800506s
17. Juang SH, Chiang CY, Liang FP, Chan HH, Yang JS, et al. Mechanistic study of tetrahydrofuran- acetogenins in triggering endoplasmic reticulum stress response-apotoposis in human nasopharyngeal carcinoma. Sci Rep. 2016; 6: 39251.
18. Abadie R, Medina O, Ruiz L, Alvaro T, Ayala O. Actividad antibacteriana de extractos vegetales frente a cepas intrahospitalarias, Iquitos-Perú. Revista ECI Perú. 2014; 11 (1): 31-8.
19. Pinto N, Campos LM, Evangelista ACS, Lemos ASO, Silva TP, Melo RCN, et al. Antimicrobial Annona muricata L. (soursop) extract targets the cell membranes of Gram-positive and Gram-negative bacteria. Industrial Crops and Products 2017; 107: 332-40.
20. Solomon-Wisdom GO, Ugoh SC, Mohammed B. Phytochemical Screening and Antimicrobial activities of Annona muricata (L) leaf extract. American Journal of Biological, Chemical and Pharmaceutical Sciences. 2014; 2 (1): 1-7.
21. Troncoso C, Pavez M, Santos A, Salazar R, Barrientos L. Implicancias estructurales y fisiológicas de la célula bacteriana en los mecanismos de resistencia antibiótica. Int j. morphol 2017; 35(4): 1214-23.
22. Aranda - Salazar R, Torre Y, Alanis BA, Pérez LA, Waksman N. Evaluación de la actividad biológica de productos herbolarios comerciales. Medicina Universitaria. 2009; 11 (44): 156- 64.

